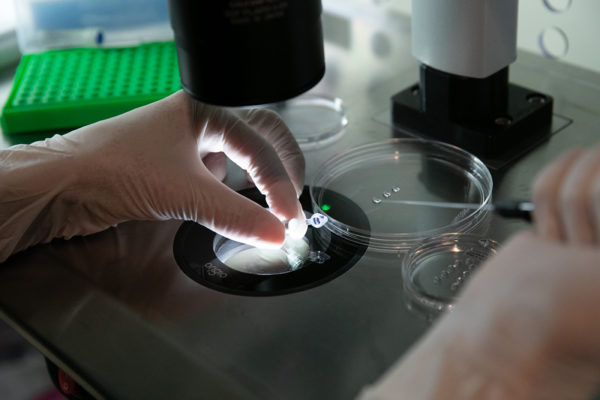
Surgery- maa fartility

Designed by specialist
Designed by specialists, Our IVF centre is the first advanced fertility hospitals in Yelahanka.

Male infertility is real and is more common, the problem lies with the man in about 30-40% of the cases where couples have trouble conceiving. Minimally, the initial screening evaluation of the male partner in an infertile couple should include at least one semen analysis. Semen analysis is the most important and the basic initial screening test for male infertility.
If a couple has trouble getting pregnant, one among the list of important tests the doctor suggests is Semen Analysis. Male infertility also plays a part in about 40% of all infertility cases. Here are the reasons for, and benefits of Sperm Analysis.
Maa fertility has the best team of specialists with more than 8+ years of global experience, providing you with the best-in-class treatment.
Maa Fertility is the one-stop solution for all kinds of male and female infertility solutions; one of the best fertility clinics.
We step into patient’s shoes to understand the stress and assist them through our expert counselling.
We envision a futuristic treatment to create a happy and healthy life. Proven High Success Rates from over 8+ years.
Patient Satisfaction and safety are the first priority at Maa Fertility. We’re well supported by an experienced team of staff.
Evidence-based approaches with Transparency and ethics at each step of treatment make Maa Fertility centre a go-to destination for Fertility treatment.
A man’s sperm is collected and tested in a lab. This is to test and check the volume and the sperm quality. Semen Analysis Test determines and detects fertility issues in men.
Semen Analysis is used to analyse male infertility issues. It is mostly used to detect sperm quality and volume.
Depending on the sperm quality, volume and movement, the doctors at Maa Fertility would advise the patient with medicines, surgeries or therapies.
Maa Fertility centre has been in the field of infertility for the past 8 years. We are one of the leading fertility hospitals in Bangalore, India. With a vision to provide personalized top-class fertility care for our patients.
Designed by specialists, Our IVF centre is the first advanced fertility hospitals in Yelahanka.
We constantly work to fulfil your dreams, count your success stories as our own.
We, at Maa Fertility constantly work to deliver secured and safe fertility services.
Maa Fertility is well equipped for a futuristic approach towards reproductive health.

helped many individuals regain their personal satisfaction and quality of life. Read all other patient stories below.
All copyrights © reserved to Maa Fertility Center